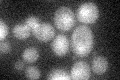
YMR224C
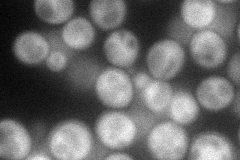
YMR224C
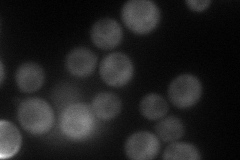
YMR224C
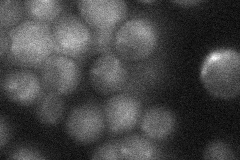
YMR224C
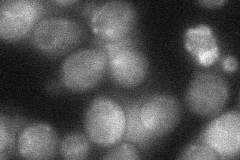
YMR224C
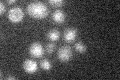
YMR224C

View description
Subunit of a complex with Rad50p and Xrs2p (MRX complex) that functions in repair of DNA double-strand breaks and in telomere stability, exhibits nuclease activity that appears to be required for MRX function; widely conserved
Localization:
Intensity:
Fold change:
Significance:
-
C’ GFP library in SD
nucleus17.99 -
N' NOP1pr-GFP in SD
cytosol66.6866 -
N' TEF2pr-mCherry in SD
cytosol63.0597 -
N' NATIVEpr-GFP in SD
below threshold18.5245 -
N' TEF2pr-VC and Cyto-VN in SD
cytosol30.7921 -
C’ GFP library in SD+DTT

nucleus17.650.98No -
C’ GFP library in SD+H2O2

nucleus21.061.17No -
C’ GFP library in Starvation Media
nucleus18.341.01No -
C’ GFP library on the background of Pup2-DaMP

nucleus -
C’ GFP library on the background of CCT mutant

nucleus18.92961.05156No
